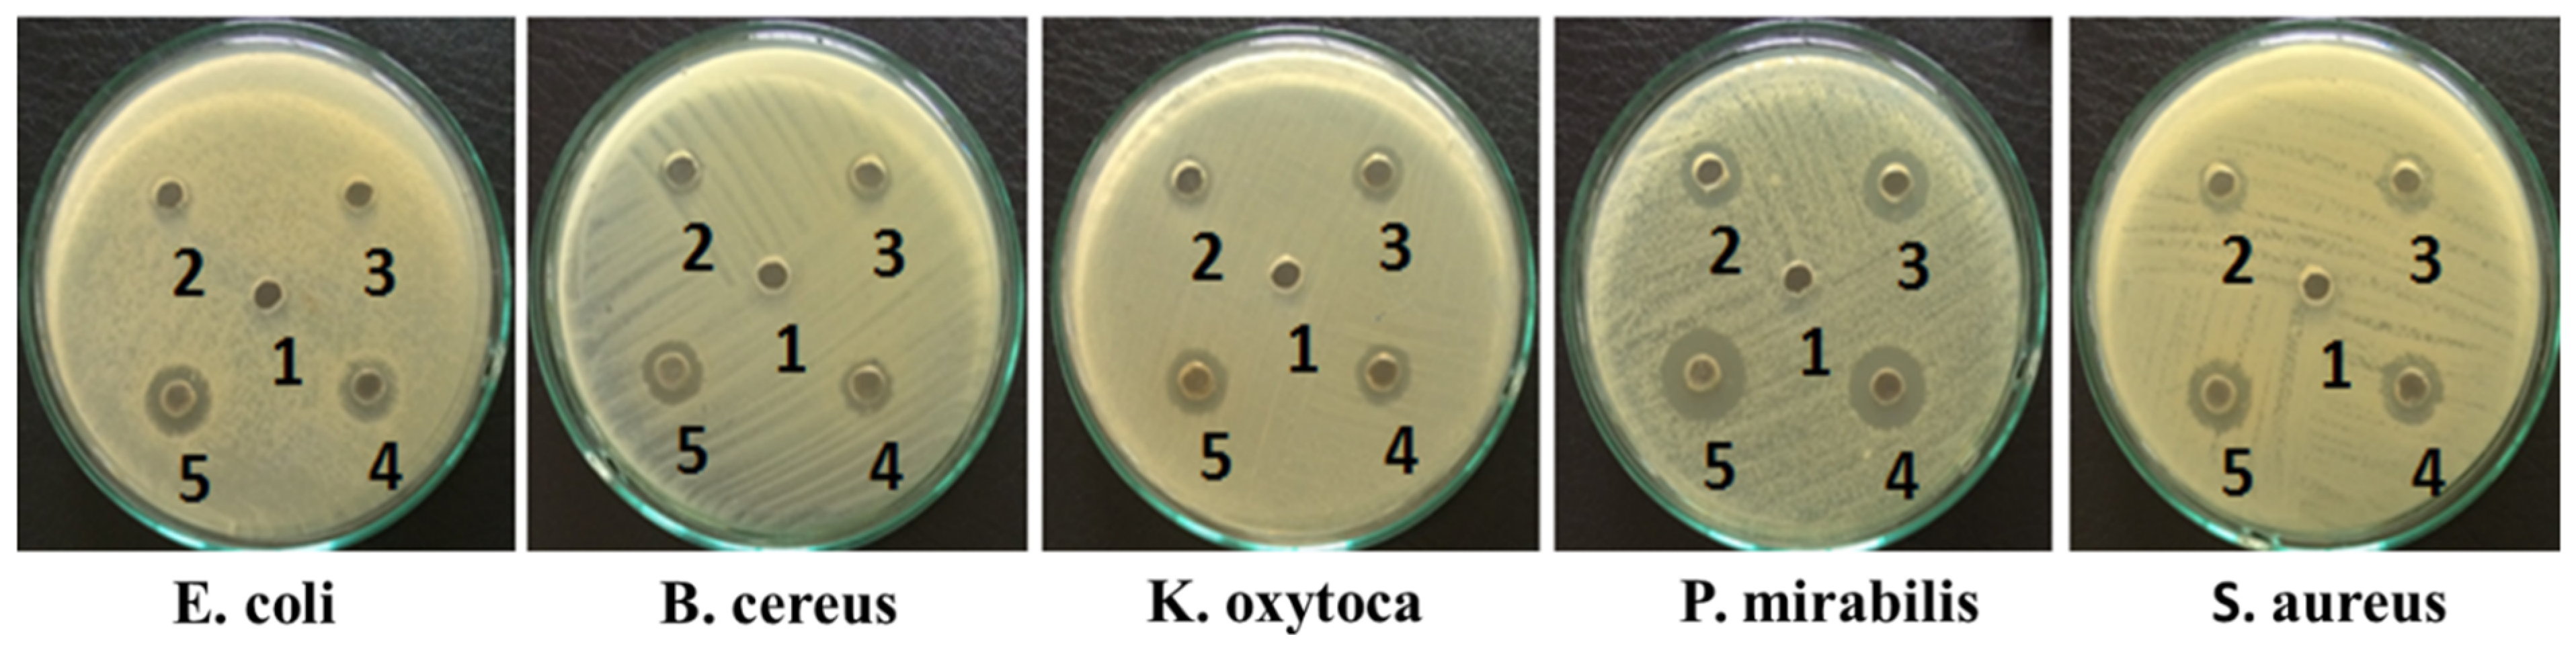
Molecules 25 04252 g001

3.2. Synthesis of Aldimine Ligands (HL1–3)
Three aldimine ligands were prepared and subsequently used to synthesize complexes with Co (II), Ni (II), Cu (II) and Zn (II). The detailed physico-chemical analysis is given in
Tables S1–S3.
3.2.1. (E)-2-((4-chloro-2-hydroxybenzylidene)amino)-3,4-dimethyl-5-phenylcyclopent-2-en-1-one (HL1)
This ligand was prepared by mixing the ethanolic solution (25 mL) of 4-amino-2,3-dimethyl-1-phenyl-3-pyrozoline-5-one (2.03 g, 10 mmol) with an ethanolic solution of (25 mL) 4-chloro-2-hydroxy benzaldehyde (1.56 g, 10 mmol) in methanol (5 mL). The mixture was placed in a 100 mL round bottom flask connected with an external condenser and refluxed for 30 min. Upon cooling on ice, yellow precipitates were formed, filtered, washed with ethanol, and stored in vacuo over silica gel.
Yellow amorphous solid, yield, 75%; m.p. 250–254 °C. Elemental analysis of CHN for C20H18ClNO2: C 70.69; H 5.34; N 4.12%. Found: C 70.65; H 5.28; N 3.90%. 1H-NMR spectrum (300 MHz, DMSO-d6) δH, ppm: 2.46 (1H, s, Ph), 3.196 (s, Me), 3.35 (s, Me), 7.5 (3H, t, Ph J = 8.1 Hz), 7.8 (2H, d, Ph J = 8.7 Hz), 9.56 (1H, s, –CH=N–); 13C-NMR spectrum (75 MHz, DMSO-d6) δC, ppm: 14.3 (C20, Me), 15.9 (C19, Me), 58.1 (C10), 126.1 (C14, Ph), 128 (C12, C16, Ph), 132, 129 (C4, C6, C13, C15, Ph), 130.6 (C7, C3, Ph), 131.9 (C2, Ph), 132.9 (C8), 136.6 (C5, Ph), 139.3 (C11, Ph), 146.8 (C18), 163.7 (C1 C=N), 187.6 (C9, C=O). Electrical Conductance (μS/cm) 3.55.
3.2.2. (Z)-3-((4-chlorobenzylidene)amino)-4-hydroxy-5-nitrobenzenesulfonic acid (HL2)
For preparing ligand HL2, the ethanolic solution (25 mL) 5-nitro-2-aminophenol-4-sulfonic acid (2.34 g, 10 mmol) was mixed with an ethanolic solution of (25 mL) of 4-chlorobenzaldehyde (1.4 g, 10 mmol) in methanol (5 mL). The mixture was placed in a 100 mL round bottom flask connected with an external condenser and refluxed for 30 min. Upon cooling on ice, brown precipitates were formed, filtered, washed with ethanol, and stored in vacuo over silica gel.
Brown amorphous solid, yield, 79%; m.p. 125–128 °C. Elemental analysis of CHN for C13H9ClN2O6S: C 43.77; H 2.54; N 7.85%. Found: C 43.55; H 2.50; N 7.67%. 1H-NMR spectrum (300 MHz, DMSO-d6) δH, ppm: 3.51 (1H, s, SO3H), 6.9 (1H, d, J = 8.7 Hz Ph), 7.2 (1H, t, J = 4.2 Hz, Ph), 7.4 (2H, d, J = 8.4 Hz, Ph), 7.8 (2H, d, J = 8.4 Hz, Ph), 8.5 (1H, s, C=N), 10 (1H, s, OH); 13C-NMR spectrum (75 MHz, DMSO-d6) δC, ppm: 116.19 (C12), 116.23 (C13), 125.08 (C4, C6), 128.81 (C3, C7), 129.31 (C2), 130.11 (C-Cl, C5), 133.86 (C-NO2, C10), 135.82 (C12, C-SO3H), 138.22 (C8), 150.96 (C9, C-OH, Ph), 156.75 (C=N). Electrical Conductance (μS/cm) 2.3.
3.2.3. 2,2′-((1,2-phenylenebis(azaneylylidene))bis(methaneylylidene))diphenol (HL3)
The ethanolic solution (25 mL) of salicylaldehyde (2.44 gm; 20 mmol), with an ethanolic solution of (25 mL) (1.08 gm; 10 mmol), was dissolved in methanol (5 mL) in the presence acetic acid as catalyst. The mixture was placed in a 100 mL round bottom flask connected with an external condenser and refluxed for 30 min. Bright yellow precipitates were obtained on cooling the reaction mixture, and the precipitates were filtered, washed with ethanol, and stored in vacuo over silica gel.
Bright yellow amorphous solid, yield, 82%; m.p. 161–163 °C. Elemental analysis of CHN for C20H16N2O2: C 75.93; H 5.10; N 8.86%. Found: C 75.82; H 4.95; N 8.71%. 1H-NMR spectrum (300 MHz, DMSO-d6) δH, ppm: 6.92 (1H, m, Ph), 7.06 (1H, d, Ph, J = 8.1 Hz), 7.24 (1H, m, Ph), 7.35 (3H, m, Ph), 8.65 (1H, s, –CH=N–), 13.08 (1H, s, Phenolic); 13C-NMR spectrum (75 MHz, DMSO-d6) δC, ppm: 117.58, 118.5 (C2, Ph), 119 (C4, Ph), 119.24 (C9, Ph), 119.73 (C10, Ph), 132.36 (C3, Ph), 133.4 (C5, Ph), 142.58 (C8, Ph), 161.36 (C1, –CH=N–), 163.73 (C7 Ph). Electrical Conductance (μS/cm) 1.06.
3.3. General Method for the Preparation of the Heteroleptic Metal Complexes (ML1–3Gly)
To well stirred ethanolic solutions (20 mL) of aldimine ligands (HL1–3), equimolar amounts of metal chlorides and phenyl glycine were gradually added, maintaining the reaction mixture temperature at 60–70 °C. The resulting precipitated products were filtered, washed, and dried in vacuum over silica gel.
CoL1Gly: Velvety brown amorphous solid, yield, 80%; m.p. 185–190 °C. Elemental analysis of CHN for C28H22CoN3O4: C 64.25; H 4.24; N 8.03%. Found: C 64.04; H 4.12; N 7. 89%. Electrical Conductance (μS/cm) 18.56.
NiL1Gly: Light green amorphous solid, yield, 78%; m.p. 312–316 °C. Elemental analysis of CHN for C28H25ClNiN2O4: C 61.41; H 4.60; N 5.12%. Found: C 60.87; H 4.55; N 5.02%. Electrical Conductance (μS/cm) 31.4.
CuL1Gly: Light blue amorphous solid, yield, 77%; m.p. >330 °C. Elemental analysis of CHN for C28H25ClCuN2O4: C 60.87; H 4.56; N 5.07%. Found: C 60.58; H 4.50; N 5.16%. Electrical Conductance (μS/cm) 13.42.
ZnL1Gly: White amorphous solid, yield, 81%; m.p. >350 °C. Elemental analysis of CHN for C28H25ClZnN2O4: C 60.67; H 4.55; N 5.05%. Found: C 60.63; H 4.32; N 5.00%. Electrical Conductance (μS/cm) 27.9.
CoL2Gly: Dark brown amorphous solid, yield, 65%; m.p. >250 °C. The elemental analysis of CHN for C21H16ClCoN3O8S: C 44.66; H 2.86; N 7.44%. Found: C 44. 47; H 2.76; N 7.40%. Electrical Conductance (μS/cm) 30.7.
NiL2Gly: Dark Green amorphous solid, yield, 74%; m.p. 333–338 °C. Elemental analysis of CHN for C21H16ClCoN3O8S: C 44.68; H 2.86; N 7.44%. Found: C 44.59; H 2.85; N 7.31%. Electrical Conductance (μS/cm) 4.69.
CuL2Gly: Brown amorphous solid, yield, 76%; m.p. 217–222 °C. Elemental analysis of CHN for C21H16ClCuN3O8S: C 44.30; H 2.83; N 7.38%. Found: C 44.28; H 2.76; N 7.21%. Electrical Conductance (μS/cm) 3.42.
ZnL2Gly: Light brown amorphous solid, yield, 80%; m.p. 280–282 °C. Elemental analysis of CHN for C21H16ClCuN3O8S: C 44.15; H 2.82; N 7.36%. Found: C 43.89; H 2.65; N 7. 31%. 1H-NMR spectrum (300 MHz, DMSO-d6) δH, ppm: 3.50 (1H, s, SO3H), 3.34 (s, Me), 6.9 (1H, d, J = 8.7 Hz Ph), 7.1 (1H, t, J = 4.2 Hz, Ph), 7.3 (2H, d, J = 8.4 Hz, Ph), 7.6 (2H, d, J = 8.4 Hz, Ph), 8.7 (1H, s, C=N), 9.3 (1H, s, OH); 13C-NMR spectrum (75 MHz, DMSO-d6) δC, ppm: 117.93 (C12), 119.37 (C13), 123.36 (C4, C6), 127.34 (C3, C7), 129.29 (C2), 131.16 (C-Cl, C5), 135.41 (C-NO2, C10), 136.60 (C12, C-SO3H), 139.25 (C8), 150.75 (C9, C- OH, Ph), 160.07 (C=N). Electrical Conductance (μS/cm) 27.9.
CoL3Gly: Velvety brown amorphous solid, yield, 79%; m.p. 185–190°C. Elemental analysis of CHN for C28H22CoN3O4: C 64.25; H 4.24; N 8.03%. Found: C 64.04; H 4.12; N 7.89%. Electrical Conductance (μS/cm) 31.7.
NiL3Gly: Maroon amorphous solid, yield, 78%; m.p. >346 °C. Elemental analysis of CHN for C28H22NiN3O4: C 64.28; H 4.24; N 8.03%. Found: C 63.75; H 3.99; N 8.01%. Electrical Conductance (μS/cm) 25.4.
CuL3Gly: Dark blue amorphous solid, yield, 90%; m.p. 225–235 °C. Elemental analysis of CHN for C28H22CuN3O4: C 63.69; H 4.20; N 7.83%. Found: C 63.58; H 4.01; N 7. 83%. Electrical Conductance (μS/cm) 13.5.
ZnL3Gly: Yellow amorphous solid, yield, 89%; m.p. 220–222°C. Elemental analysis of CHN for C28H22ZnN3O4: C 63.47; H 4.19; N 7.59%. Found: C 63.40; H 3.98; N 7. 93%. 1H-NMR spectrum (300 MHz, DMSO-d6) δH, ppm: 6.5 (1H, m, Ph), 6.9 (1H, d, Ph, J = 8.1 Hz), 7.27 (1H, m, Ph), 7.4 (3H, m, Ph), 7.9 (1H, s, –CH=N–), 9.06 (1H, s, Phenolic); 13C-NMR spectrum (75 MHz, DMSO-d6) δC, ppm: 113.42, 116.93 (C2, Ph), 119.89 (C4, Ph), 123.55 (C9, Ph), 119.73 (C10, Ph), 134.78 (C3, Ph), 136.69 (C5, Ph), 139.83 (C8, Ph), 163.29 (C1, –CH=N–), 172.73 (C7 Ph). Electrical Conductance (μS/cm) 3.57.
3.5. Mechanistic Study
The reaction for the formation of the complex can be assumed as
The equation for the dissociation of the complex, and stability constant (K
st) can be expressed as:
| MmLn | → | mM | + | nL | |
| C | | 0 | | 0 | Initial concentration |
| | | | | Equilibrium concentrations |
where ‘
’ represents the degree of dissociation of the compound. ‘C’ is the initial concentration.
To find the stoichiometry and formation constant of the complex, metal ion solution and reagent solutions were mixed to give the following nine set of solutions:
Metal ion solution (mL) 0.5, 1.0, 1.5, 2.0, 2.5, 3.0, 3.5, 4.0 and 4.5
Reagent solution (mL) 4.5, 4.0, 3.5, 3.0, 2.5, 2.0, 1.5, 1.0 and 0.5.
The solutions were suitably diluted with distilled water up to 100 or 250 mL in volume to record the spectra. Job’s method was applied for stoichiometric ratio and stability constant determination of the complexes. The curve is obtained with a maximum corresponding to the specific value of mole fraction, which gives the stoichiometric mole fraction indicating the stoichiometry of the complex (M: L).
A
max is the absorbance value of the maxima at experimental curve represents the maximum quantity of the complex formed with a degree of dissociation (α), and A
ο is absorbance value corresponding to intersect point of theoretical straight lines. A
α is the absorbance value of the part of a dissociated concentration of the complex that represents the difference between A
ο and A
max;
To estimate the stability constant, the degree of dissociation of complex (α) is calculated in the following manner
where ε is molar absorptivity (calculated for each compound by using the reported method [
31]), b is a cell thickness, and C is a concentration of the complex at stoichiometry point.